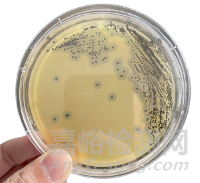
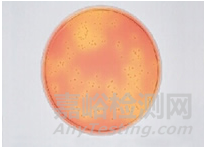
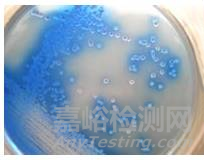
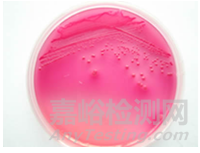
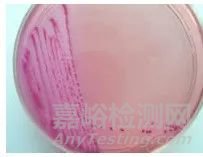
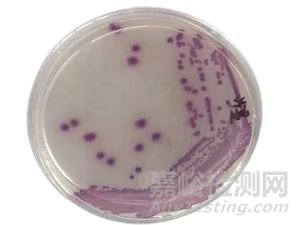
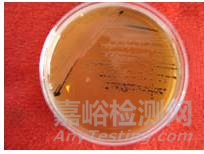
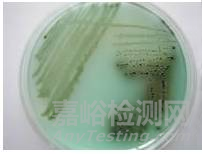
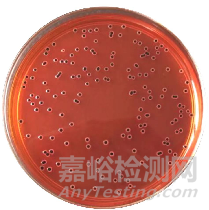
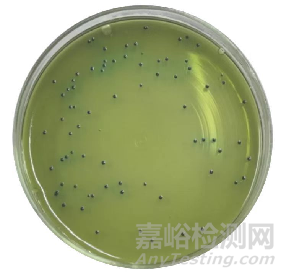
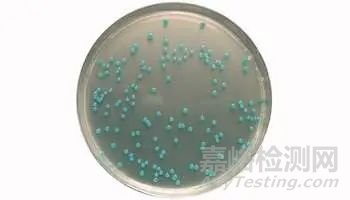
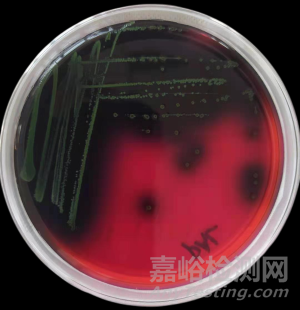
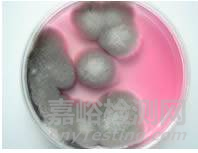
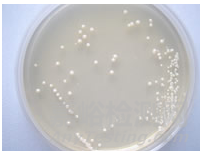

微生物菌落很多樣����,今天小編匯總一下微生物在不同培養(yǎng)基上的典型菌落形態(tài),一起學(xué)習(xí)啦�!
一、金黃色葡萄球菌
1. 金黃色葡萄球菌在BP瓊脂上典型特征
特征描述: 金黃色葡萄球菌呈圓形��,表面光滑�、凸起、濕潤��,直徑 2-3mm ����。灰黑色至黑色�,有光澤,常有淺色(非白色)的邊緣,周圍繞以不透明圈(沉淀)�,其外常有一清晰帶(卵磷脂環(huán))。當(dāng)用接種針觸及菌落時具有黃油樣粘稠感��。有時可見到不分解脂肪的菌株��,除沒有不透明圈和清晰帶外�,其他外觀基本相同�。從長期貯存的冷凍或脫水食品中分離的菌落,其黑色常較典型菌落淺些��,且外觀可能較粗糙��,質(zhì)地較干燥�。
2. 金黃色葡萄球菌在金黃色葡萄球菌顯色培養(yǎng)基上典型特征
特征描述: 典型的金黃色葡萄球菌為灰黑色菌落��,其外圍有一不透明圈��,本培養(yǎng)基用于直接鑒定金黃色葡萄球菌�,如果在18-24小時沒有出現(xiàn)典型菌落,需再培養(yǎng)18-24小時�。有時金黃色葡萄球菌不顯灰黑色,但其外圍有一不透明圈����。
3. 金黃色葡萄球菌在甘露醇高鹽瓊脂培養(yǎng)基上典型特征
特征描述: 金黃色葡萄球菌顯黃色��,其外圍有一黃色的暈環(huán)����。
二��、大腸桿菌
1. 大腸桿菌在大腸桿菌/大腸菌群顯色培養(yǎng)基上典型特征
特征描述: 大腸桿菌典型菌落為藍(lán)色至紫色����,大腸菌群為粉紅色菌落,其它細(xì)菌為無色菌落����。
2. 大腸桿菌O157菌在O157菌顯色培養(yǎng)基上典型特征
特征描述: 典型O157:H7菌顯紫色,大腸桿菌和大腸菌群顯暗藍(lán)色����。
3.大腸桿菌在伊紅美藍(lán)瓊脂(EMB)上典型特征
特征描述: 大腸桿菌典型菌落為藍(lán)色至紫色,大腸菌群為粉紅色菌落��,其它細(xì)菌為無色菌落����。
4.大腸桿菌在月桂基硫酸鹽胰蛋白胨肉湯(LST)上典型特征
特征描述: 大腸桿菌分解乳糖產(chǎn)生氣體 ,小倒管內(nèi)收集有氣泡。
三����、大腸菌群
1.大腸菌群在去氧膽酸鹽瓊脂(DC)上典型特征
特征描述:典型菌落為紅色 , 菌落周圍有紅色的膽鹽沉淀環(huán)。菌落直徑為 2-3mm 或更大����。
2.大腸菌群在結(jié)晶紫中性紅瓊脂(VRBA)上典型特征
特征描述:典型菌落為紫紅色 , 菌落周圍有紅色的膽鹽沉淀環(huán)。菌落直徑為 0.5mm 或更大�。
四、沙門氏菌
1. 沙門氏菌在沙門氏菌顯色培養(yǎng)基上典型特征
特征描述: 典型沙門氏菌顯亮紅色�,大腸桿菌顯藍(lán)色綠色,枸櫞酸桿菌顯紫色�,其它細(xì)菌顯黃色或無色��。
2.沙門氏菌在膽硫乳瓊脂(DHL瓊脂)上典型特征
特征描述: 沙門氏菌在37℃培養(yǎng)22-24小時后��,呈無色半透明有黑色中心或幾乎全為黑色�。有些菌株呈無色半透明。
3. 沙門氏菌在亞硫酸鉍瓊脂(BS瓊脂)上典型特征
特征描述: 沙門氏菌在37℃培養(yǎng)24-48小時后�,呈棕褐色或灰色至黑色,有時有金屬光澤����,周圍培養(yǎng)基呈棕色或黑色,有些菌株呈灰綠色,周圍培養(yǎng)基不變或微變暗�。
4.沙門氏菌在XLD瓊脂上典型特征
特征描述: 沙門氏菌在35℃培養(yǎng)24-48小時后,呈無色半透明有黑色中心或幾乎全為黑色�。
5. 沙門氏菌在SS瓊脂上典型特征
特征描述: 沙門氏菌在 37 ℃ 培養(yǎng)18-24小時后,呈無色透明菌落有黑色中心��。
6. 沙門氏菌在HE瓊脂上典型特征
特征描述: 沙門氏菌在37℃培養(yǎng)18-24時后��,沙門氏菌�、亞利桑那菌和變形桿菌為藍(lán)綠色至藍(lán)色、有或無黑色中心的菌落�。
五、李斯特氏菌
1.單增李斯特氏菌在李斯特氏菌顯色培養(yǎng)基上典型特征
特征描述:
單增李斯特氏菌37℃培養(yǎng)24-28小時�,平板上出現(xiàn)藍(lán)色菌落,菌落周圍有一不透明環(huán)�。綿羊李斯特氏菌37 ℃培養(yǎng)48小時,平板上出現(xiàn)藍(lán)色菌落����,菌落周圍有一不透明環(huán)。西爾李斯特氏菌37℃培養(yǎng)24-48小時��,平板上出現(xiàn)藍(lán)色菌落����,菌落周圍沒有不透明環(huán)��。在食品檢測中綿羊李斯特氏菌非常少見����。
2.李斯特氏菌在PALCAM瓊脂上曲型特征
特征描述: 李斯特氏菌在35℃培養(yǎng)24-48小時后��,灰綠色菌落����。其外圍有一黑色環(huán)。
六��、副溶血性弧菌
1.副溶血性弧菌在弧菌顯色培養(yǎng)基上典型特征
特征描述:典型副溶血性弧菌顯藍(lán)色至藍(lán)綠色 �, 霍亂弧菌和其它弧菌顯無色。
2.副溶血性弧菌在TCBS培養(yǎng)基上典型特征
特征描述:典型霍亂弧菌菌落為黃色��,扁平��,真徑2-3mm �;副溶血弧菌菌落呈圓形��,邊緣整齊����、濕潤��、稍混濁����、半透明�,多數(shù)具尖心、斗笠狀����,藍(lán)綠色菌落,直徑2-4mm��。
七�、蠟樣芽胞桿菌
蠟樣芽孢桿菌在MYP瓊脂上典型特征
特征描述: 蠟樣芽孢桿菌顯白色 ,其外圍有粉紅色的暈環(huán)��。
八�、霉菌在孟加拉紅培養(yǎng)基上典型特征
特征描述: 霉菌在孟加拉紅培養(yǎng)基上典型特征為灰色菌落,有黑色孢子�。
九、酵母菌
1. 酵母菌在孟加拉紅培養(yǎng)基上典型特征
特征描述: 酵母菌在孟加拉紅培養(yǎng)基上典型特征為紅色菌落��。
2. 酵母菌在馬鈴薯葡萄糖瓊脂上典型特征
特征描述: 酵母菌在馬鈴薯葡萄糖瓊脂上在28 ℃培養(yǎng)48小時后����,呈乳白色菌落�,有突起�。